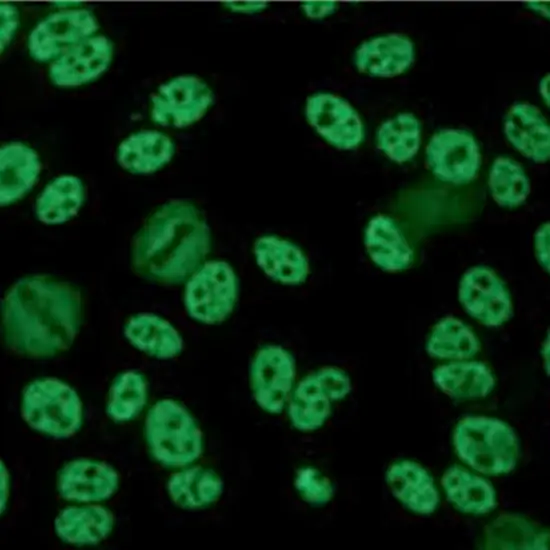

Book SM and RNP Antibody Appointment Online Near me at the best price in Delhi/NCR from Ganesh Diagnostic. NABL & NABH Accredited Diagnostic centre and Pathology lab in Delhi offering a wide range of Radiology & Pathology tests. Get Free Ambulance & Free Home Sample collection. 24X7 Hour Open. Call Now at 011-47-444-444 to Book your SM and RNP Antibody at 50% Discount.
SM and RNP Antibody is a blood test used for patients with autoimmune disorder mixed connective tissue disease. In this disorder, the body’s immune system attacks its cells and causes damage. The patient experiences symptoms of systemic lupus erythematosus, polymyositis, and sclerodermas such as fever, fatigue, pain in joints, inflammation of joints, and muscle weakness.
• Anti-Ribonucleic Protein Antigen
• Anti-ENA Antibody
• ENA Antibodies
• Ribonuclear Protein Antibody
• Anti-Smith Antibody
• RNP Antibody
Doctors prescribe Sm/RNP Antibodies to detect and diagnose
No special preparation is required for the Sm/RNP Antibody Test.
You need to give 2ml of blood for the procedure.
Result
The positive result indicates Antibody is detected
A negative result indicates no antibody is detected
| Test Type | SM and RNP Antibody |
| Includes | SM and RNP Antibody Test (Pathology Lab) |
| Preparation | |
| Reporting | Within 24 hours* |
| Test Price |
₹ 1105
|

Early check ups are always better than delayed ones. Safety, precaution & care is depicted from the several health checkups. Here, we present simple & comprehensive health packages for any kind of testing to ensure the early prescribed treatment to safeguard your health.